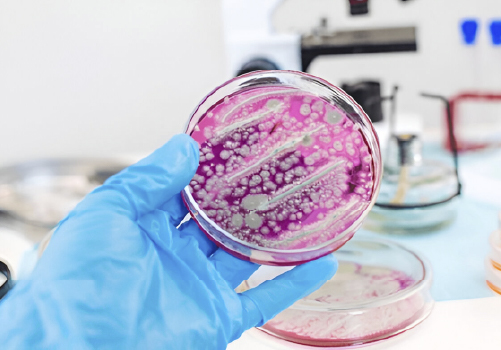
Epidemiología y economía veterinaria 10 bacteriologia2

Epidemiología y economía veterinaria
Diagnóstico preciso y servicios especializados en epidemiología veterinaria
SOBRE EL LABORATORIO
Laboratorio orientado a la investigación, asesoría y consultoría técnica en salud animal, salud pública y zoonosis, mediante el diseño y desarrollo de estudios epidemiológicos, moleculares y estadísticos, tanto en campo como en laboratorio.
Descripción detallada:
Se especializa en el diseño y ejecución de estudios transversales y longitudinales, ensayos clínicos controlados, análisis espacial de enfermedades, modelamiento matemático y procesamiento de bases de datos. Brinda asesoría y consultoría técnica a instituciones públicas y privadas, contribuyendo a la generación de evidencia científica para la vigilancia, prevención y control de enfermedades de importancia veterinaria y zoonótica.
Líneas de trabajo
Líneas de investigación
- Epidemiología veterinaria
- Epidemiología molecular
- Bioestadística
- Zoonosis y educación sanitaria
NOTICIAS
Conoce las últimas noticias que tenemos para ti
Organigrama
Personal
COMPROMISO CON LA CALIDAD
Norma ISO IEC 25
Nuestro laboratorio promueve la cultura de la calidad de acuerdo a la norma ISO IEC 25, garantizando la confiabilidad y precisión de nuestros resultados.
"Velamos por la salud animal y salud pública a través de servicios de diagnóstico de alta calidad, precisión y confiabilidad, contribuyendo al bienestar de la comunidad y al desarrollo sostenible del sector pecuario."
CONTACTO Y ATENCIÓN
Equipo Directivo
Personal responsable de la gestión de Epidemiología y economía veterinaria
Información de Contacto
Detalles para comunicarse con el laboratorio de Epidemiología y economía veterinaria
Horario de Atención
Horario: Lunes a Viernes
8:00 am a 4:00 pm